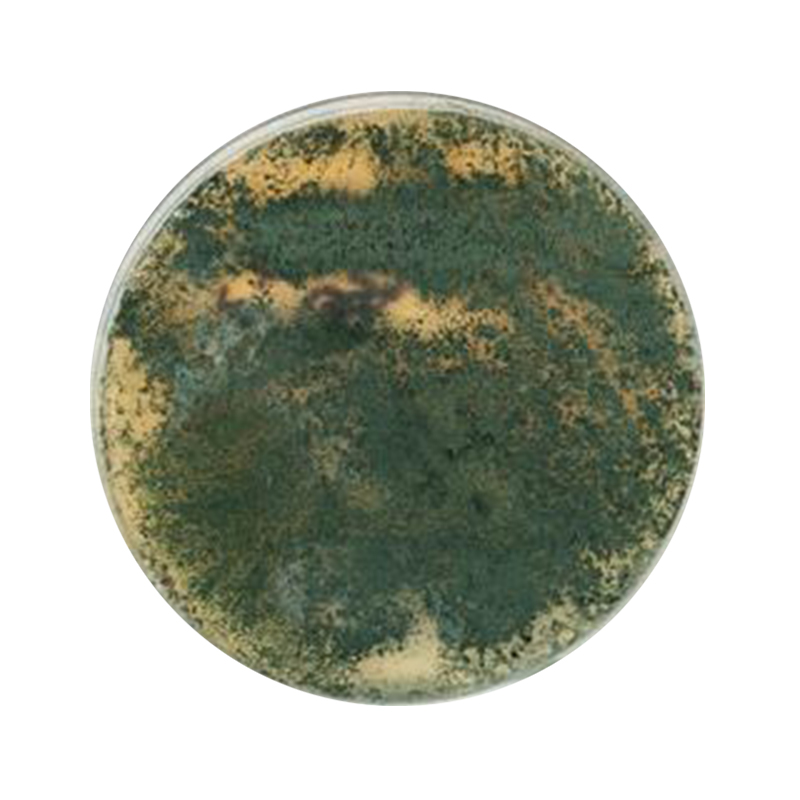

Trichoderma Asperellum
Strain cultivation process
Freeze preservation of bacterial strains

Laboratory testing of bacterial strains

Use rice as the culture medium

Cultivation -- growth ---- formation

Ms Wendy Lee
Mobile&Wechat&Whatsapp : 0086 13562692198
Email :yuedongbiotech@aliyun.com
Ms Jeff Wang
Mobile&Wechat&Whatsapp : 0086 13563622867
Email :wfyuedong@aliyun.com
Ms Sundy Lee
Mobile&Wechat&Whatsapp : 0086 15965090376
Email :yuedongsundy@aliyun.com


